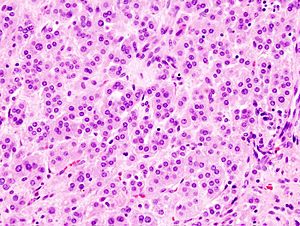

Adrenal cortical adenoma
Jump to navigation
Jump to search
| Adrenal cortical adenoma | |
|---|---|
| Diagnosis in short | |
Adrenal cortical adenoma. H&E stain. | |
| LM DDx | adrenal cortical nodule, adrenal cortical hyperplasia, adrenal cortical carcinoma |
| IHC | calretinin, inhibin |
| Molecular | cortisol-producing (PRKACA, GNAS1, MENIN, ARMC5, APC, FH, PRKAR1A, PDE11A, PDE8B), aldosterone-producing (KCNJ5, ATP1A1, ATP2B3, CACNA1D, CTNNB1), non-secreting (CTNNB1) |
| Site | adrenal gland |
|
| |
| Prevalence | relatively common |
| Blood work | +/-cortisol elevation, +/-aldosterone elevation |
| Radiology | adrenal mass, HU<10 |
| Prognosis | benign |
| Treatment | followup or surgical excision |
Adrenal cortical adenoma, also adrenocortical adenoma and adrenal adenoma, is a relatively common benign pathology of the adrenal gland.
General
Epidemiology:
- Often an incidental finding.
Pathologic/clinical:
- May be hormonally active.
- Can be a cause of hypertension.[1]
- Radiologists are good at identifying adenomas, as they are usually lipid rich and have a characteristic low HU signal (<10 HU[2]).
Indications for excision:[4][5]
- Lesions >30 mm.
- Hormonally active.
- Non-incidental finding. (???)
- Adrenal vein sampling (AVS) suggestive of adenoma.[1]
Notes:
- Cushing disease is due to the ACTH over-production by the pituitary.
- In cortisol producing tumours (Cushing syndrome): atrophy of the non-hyperplastic cortex (due to feedback inhibition from the pituitary gland).
Serology and genes
The serology in adenoma has been associated with certain genes:[6]
| Serology | Gene(s) |
|---|---|
| non-secreting adenoma | CTNNB1 |
| cortisol-producing | PRKACA, GNAS1, MENIN, ARMC5, APC, FH, PRKAR1A, PDE11A, PDE8B |
| aldosterone-producing | KCNJ5, ATP1A1, ATP2B3, CACNA1D, CTNNB1 |
Note:
- Androgen producing adenomas are rare; androgen production more common in adrenal cortical carcinoma.[6]
Microscopic
Classic features:
- Well-defined cell borders.
- Clear cells (abundant, finely vacuolated cytoplasm)
- Polygonal pink cells.
- Most of the nuclei are bland, central and round.
- May have foci of necrosis/degeneration and nuclear atypia.
Note:
- In aldosterone producing tumours:
- May extend outside of the capsule (should not be diagnosed as adrenal cortical carcinoma).
- No atrophy of non-hyperplastic cortex.
- May show spironolactone bodies if hypertension treated with spironolactone prior to surgery.
DDx:
- Adrenal cortical nodule.[7]
- Adrenal cortical hyperplasia.
- Hyperplasia is multifocal.[8]
- Adrenal cortical carcinoma - see Weiss criteria below.
Weiss criteria
The diagnosis of adrenal cortical carcinoma requires three of the following:[9][10]
- High nuclear grade.
- High mitotic rate; >5/50 HPF (@ 40X obj.) - definition suffers from HPFitis.
- Atypical mitoses.
- Cleared cytoplasm in <= 25% of tumour cells.
- Sheeting (diffuse architecture) in >= 1/3 of tumour cells.
- Necrosis in nests.
- Venous invasion.
- Adrenal sinusoid invasion; lymphovascular space invasion within the adrenal gland.
- Capsular invasion.
Images
IHC
Features:[11]
- Calretinin +ve.
- Inhibin +ve.
Note:
- Calretinin and inhibin in combination are useful for adrenal versus pheochromocytoma.[11]
Sign out
Adrenal Gland, Right, Adrenalectomy: - Adrenal cortical adenoma.
Microscopic
The sections show a benign adrenal gland with an expanded cortex. Clearing of the cytoplasm is present in the cortex. None of the following are present in the cortex: High nuclear grade, high mitotic rate (mitotic activity >5/50 HPF, where 1 HPF~=0.2376 mm*mm), atypical mitoses, sheeting, necrosis, sinusoidal invasion, venous invasion, capsular invasion.
See also
References
- ↑ 1.0 1.1 1.2 Myint, KS.; Watts, M.; Appleton, DS.; Lomas, DJ.; Jamieson, N.; Taylor, KP.; Coghill, S.; Brown, MJ. (Jun 2008). "Primary hyperaldosteronism due to adrenal microadenoma: a curable cause of refractory hypertension.". J Renin Angiotensin Aldosterone Syst 9 (2): 103-6. doi:10.3317/jraas.2008.015. PMID 18584586.
- ↑ Tenenbaum, F.; Lataud, M.; Groussin, L. (Apr 2014). "[Update in adrenal imaging].". Presse Med 43 (4 Pt 1): 410-9. doi:10.1016/j.lpm.2014.02.002. PMID 24636681.
- ↑ Fujiwara, M.; Murao, K.; Imachi, H.; Yoshida, K.; Muraoka, T.; Ohyama, T.; Kushida, Y.; Haba, R. et al. (Oct 2010). "Misdiagnosis of two cases of primary aldosteronism owing to failure of computed tomography to detect adrenal microadenoma.". Am J Med Sci 340 (4): 335-7. doi:10.1097/MAJ.0b013e3181e95587. PMID 20881759.
- ↑ Luton, JP.; Martinez, M.; Coste, J.; Bertherat, J. (Jul 2000). "Outcome in patients with adrenal incidentaloma selected for surgery: an analysis of 88 cases investigated in a single clinical center.". Eur J Endocrinol 143 (1): 111-7. PMID 10870039.
- ↑ Liu, XK.; Liu, XJ.; Dong, X.; Kong, CZ. (Jun 2008). "[Clinical research about treatment for adrenal incidentalomas]". Zhonghua Wai Ke Za Zhi 46 (11): 832-4. PMID 19035218.
- ↑ 6.0 6.1 Mahmood E, Loughner CL, Anastasopoulou C. PMID 30969728.
- ↑ Thompson, Lester D. R. (2006). Endocrine Pathology: A Volume in Foundations in Diagnostic Pathology Series (1st ed.). Churchill Livingstone. pp. 200. ISBN 978-0443066856.
- ↑ IAV. 18 February 2009.
- ↑ Jain M, Kapoor S, Mishra A, Gupta S, Agarwal A (2010). "Weiss criteria in large adrenocortical tumors: a validation study". Indian J Pathol Microbiol 53 (2): 222–6. doi:10.4103/0377-4929.64325. PMID 20551521.
- ↑ Weiss, LM. (Mar 1984). "Comparative histologic study of 43 metastasizing and nonmetastasizing adrenocortical tumors.". Am J Surg Pathol 8 (3): 163-9. PMID 6703192.
- ↑ 11.0 11.1 Jorda M, De MB, Nadji M (March 2002). "Calretinin and inhibin are useful in separating adrenocortical neoplasms from pheochromocytomas". Appl. Immunohistochem. Mol. Morphol. 10 (1): 67–70. doi:10.1097/00129039-200203000-00012. PMID 11893039.







